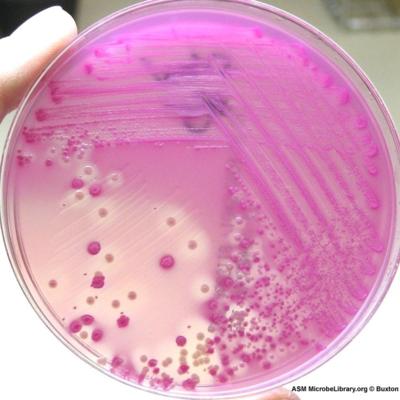

Aνάπτυξη είδους Salmonella ανάμεσα σε φυσιολογική εντερική χλωρίδα σε άτομο με επίμονη διάρροια.Αυτές οι αποικίες διασπούν την λακτόζη (ροζ χρώμα) και παράγουν υδρόθειο H2S (μαύρο χρώμα).
Ανάπτυξη φυσιολογικής χλωρίδας εντέρου μετά καλλιέργεια 24 ωρών .Διακρίνονται δύο είδη αποικιών που δεν διασπούν την λακτόζη -άχρωμες-και ένα είδος που διασπά την λακτόζη -ροζ.Κανένα από αυτά τα μικρόβια δεν ταυτοποιήθηκε σαν παθογόνο υπεύθυνο για γαστρεντερίτιδα.





